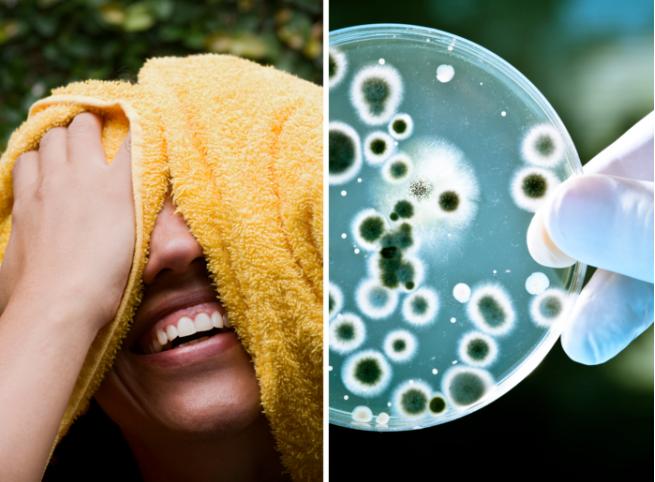
txt

مع انتشار عدوى بكتيريا المكورات العنقودية أعلنت المملكة المتحدة، أول أمس، تسجيل 5 وفيات خلال 7 أيام بسبب العدوى لدى أطفال دون سن الـ 10، الأمر الذي أثار مخاوف صحية من احتمال تحور هذا النوع من الأمراض.

المكورات العنقودية مهددة للحياة
تحدُث عدوى المكورات العنقودية بسبب بكتيريا المكورة العنقودية، وهذه الأنواع من البكتيريا تظهر عادةً على الجلد أو داخل الأنف لدى كثير من الأصحاء، ولا تسبب في أغلب الأحيان أي مشكلات، أو أنها تؤدي إلى حالات عدوى جلدية بسيطة نسبيا.
وقد تصبح حالات عدوى المكورات العنقودية مهددة للحياة إذا أصابت البكتيريا الأعضاء الداخلية للجسم، أو دخلت إلى مجرى الدم أو المفاصل أو العظام أو الرئتين أو القلب، ويتزايد عدد الأصحاء الذين يتعرضون للإصابة بحالات عدوى المكورات العنقودية المهددة للحياة.
وأعلنت الصحف البريطانية من يومين عن وفاة طفل متأثرًا ببكتيريا Strep A والمعروفة بعدوى المكورات العقدية، وذلك بعد إصابة عدد كبير من الأطفال بتلك العدوى في مدارس مختلفة في أنحاء المملكة.
وتوفي الطفل محمد إبراهيم البالغ من العمر 7 سنوات متأثرًا بعدوى البكتيريا العنقودية، ليكون الطفل الرابع الذي توفي بسبب المرض بعد الإبلاغ عن وفاة 3 تلاميذ في خلال الأسابيع الماضية القليلة.
الطفح الجلدي وآلم بالمعدة
ووصفت والدة الطفل محمد الذي توفي إثر الإصابة بالبكتيريا، لمصادر إعلامية قائلة: كان الطفح الجلدي أسفل الظهر أول الأعراض التي عانى منها طفلي، ثم بدأ يشعر بآلام شديدة في المعدة.
وتوفي محمد في سيارة الإسعاف وهو في طريقه إلى المستشفى، وبعد أسبوع، أظهرت نتائج فحص ما بعد الوفاة أنه مصاب ببكتيريا المكورات العنقودية "أي" في دمه.
وقالت والدة محمد: يجب أن يكون الناس أكثر وعيا بالأعراض الأولية، أعتقد أنه يجب توعية الوالدين بالأعراض والتصرف حيالها".
وأضافت، "إنها قلقة من أن الناس لا تزال غير مدركة لمدى خطورة هذا الأمر، وقيل في الأخبار أنه من النادر جدا أن يموت الأطفال بسبب هذا الالتهاب العقدي، لكنهم للأسف نسوا وقوع ستة وفيات في غضون أسبوعين من الأطفال، وأعتقد أن المزيد سيأتي إذا لم تتحرك الحكومة بسرعة ".
وتوفي ستة أطفال في المملكة المتحدة بعد إصابتهم بالعدوى البكتيرية شديدة العدوى، والتي غالبًا ما تكون خفيفة نسبيا وتسبب الحمى القرمزية، ولكنها قد تكون مميتة إذا دخلت مجرى الدم وأجزاء أخرى من الجسم.
والجدير بالذكر، ستة أطفال ماتوا حتى الساعة بسبب بكتيريا "Strep A" في بريطانيا، وحالات العدوى التي عادة ما تكون غير ضارة أعلى بخمس مرات في البلاد بين الأطفال مما كانت عليه قبل إصابة كوفيد، حيث حذرت السلطات الصحية المعنية أن تزداد حصيلة الضحايا سوءًا في الأسابيع المقبلة.

أمراض بسيطة الي فتاكه
ووفق وكالة الأمن الصحي في المملكة المتحدة، فإن هذا النوع من العدوى البكتيرية قادر على التسبب بالعديد من الأمراض، بعضها بسيط وأخرى فتاكة.
وذكرت الوكالة أن معدل الإصابة بهذه العدوى في إنجلترا هذه السنة لدى كل 100 ألف طفل تتراوح أعمارهم بين سنة واحدة و4 أعوام، كان في حدود 2.3 حالة، بينما كان هذا الرقم في حدود 0.5 خلال الفترة ما بين 2017 و2019.
وبالنسبة للأطفال الذين تتراوح أعمارهم بين 5 و9 سنوات، سجلت 1.1 حالة لكل 100 ألف طفل، مقارنة بـ0.3 بين عامي 2017 و2019.
تعليقا على هذه الأرقام، قالت هيئة خدمات الصحة والخدمات الإنسانية في المملكة المتحدة، إن التحقيقات جارية بعد ورود تقارير عن زيادة عدوى بكتيريا المكورات العنقودية أي في الجهاز التنفسي السفلي لدى الأطفال خلال الأسابيع القليلة الماضية.
أوضحت الهيئة أن البيانات الأخيرة تظهر أن حالات الحمى القرمزية التي تسببها البكتيريا لا تزال أعلى مما نراه عادة في هذا الوقت من العام، إذ تم الإبلاغ عن 851 حالة الأسبوع الماضي، مقارنة بـ 186 حالة في السنوات السابقة.

بكتيريا المكورات العنقودية
- بكتيريا توجد أحيانا داخل الحلق أو على الجلد ويحملها الكثير من الناس دون أن يدركوا ذلك، لكن يمكنهم نشره للآخرين الذين قد يصابون بالمرض.
- يمكن للناس أن يصابوا بها من خلال الاتصال الوثيق ومن السعال والعطس كما يمكن أن يحدث تفشي للمرض أحيانا في أماكن مثل المدارس ودور الرعاية.
- غالبًا ما تكون الأعراض خفيفة التهاب الحلق أو عدوى جلدية يمكن علاجها بسهولة بالمضادات الحيوية.
- لكن يمكن أن تسبب بكتيريا المكورات العنقودية Strep A العديد من المشاكل الصحية، بعضها شديد الخطورة، إحداها الحمى القرمزية، التي تصيب في الغالب الأطفال الصغار وتحتاج مرة أخرى إلى مضادات حيوية.
- فالحمى القرمزية مرض يجب الإبلاغ عنه، مما يعني أنه يجب على المهنيين الصحيين إبلاغ فرق حماية الصحة المحلية بالحالات المشتبه فيها هذا حتى يمكن علاجهم بسرعة والسيطرة على حالات تفشي المرض المحتملة.
- وتسبب الحمى القرمزية طفح جلدي وأعراض تشبه أعراض الأنفلونزا، بما في ذلك ارتفاع درجة الحرارة والتهاب الحلق وتورم غدد الرقبة، وعلى الجلد الداكن، قد يكون من الصعب اكتشاف الطفح الجلدي بصريًا ولكن سيكون له ملمس ورق الرمل قد يكون لدى الشخص المصاب بالحمى القرمزية ما يسميه الأطباء لسان الفراولة لأن مظهره يشبه إلى حد ما الفراولة.
- وفي حالات نادرة جدا يمكن أن تسبب بكتيريا المكورات العنقودية Strep A أيضا شيئا يسمى عدوى المكورات العقدية من السلالة الغازية أو iGAS ويمكن أن تكون هذه مميتة.
- وتحدث العدوى الغازية عندما تتجاوز البكتيريا دفاعات الجسم المناعية ويمكن أن يحدث هذا عندما تكون مريضا بالفعل أو عند تلقي علاجات مثل بعض أدوية السرطان، التي تؤثر على جهاز المناعة لديك.
- وتشمل العلامات التحذيرية للعدوى الغازية الحمى (ارتفاع درجة الحرارة فوق 38 درجة مئوية)، آلام شديدة في العضلات.
- ولا يتم علاج المكورات العنقودية Strep A بالمضادات الحيوية.

الجدير بالذكر، أن الأشخاص الذين تزيد أعمارهم عن 65 عاما، أو أولئك المصابين بفيروس نقص المناعة "الإيدز"، أو الذين يستخدمون المنشطات، أو الذين يعانون من مرض السكري أو أمراض القلب أو السرطان في بعض الاحيان يكونون هم الأكثر عرضة للإصابة بالعدوى.